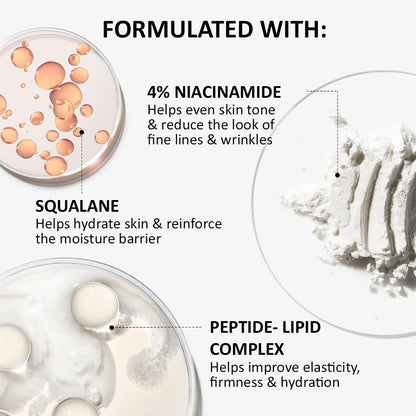
UK 🧑‍⚕️ 𝐙𝐯𝐨𝐞𝐯𝐨® Confidence in a Cream – Hydrating & Age-Defying Face Moisturiser, Visibly Reduces Fine Lines & Wrinkles

UK 🧑⚕️ 𝐙𝐯𝐨𝐞𝐯𝐨® Confidence in a Cream – Hydrating & Age-Defying Face Moisturiser, Visibly Reduces Fine Lines & Wrinkles
UK 🧑⚕️ 𝐙𝐯𝐨𝐞𝐯𝐨® Confidence in a Cream – Hydrating & Age-Defying Face Moisturiser, Visibly Reduces Fine Lines & Wrinkles
✈️Made and shipped from London,UK.
💝Achieve even, radiant skin—Money back within 90 days!
✅ Dermatologically tested and recommended by skin care professionals – gentle, hypoallergenic formula that’s safe for all skin types and all ages.
✅ Say goodbye to deep wrinkles, fine lines, puffy eyes, dark circles, sagging skin, and more.
👨⚕️ Clinically proven and certified: Hypoallergenic tested, MHRA-approved, free from harsh chemicals, GMP-certified, and dermatologically evaluated.
⭐ Trusted by over 800,000 users on Facebook, TikTok, and Instagram!

BUNDLE & SAVE
Couldn't load pickup availability
Are you worried about wrinkles from aging?
Are you worried about sagging skin?
Are you worried about unsightly creases on your body?
It's time to regain your confidence with 𝐙𝐯𝐨𝐞𝐯𝐨® Confidence in a Cream!
![]()
Discover Your Ideal Anti-Aging Solution
Whether you're looking to address deep wrinkles, fine lines, puffy eyes, dark circles, under-eye bags, dark spots, melasma, hyperpigmentation, rough texture, or sagging skin, we have an anti-aging formula that's right for you.

LET US HEAR SUCCESFUL STORIES FROM OUR VERIFIED AND SATISFIED CUSTOMERS!
Alicia Michaels from London, 63, has shared the amazing results she experienced after using 𝐙𝐯𝐨𝐞𝐯𝐨® Confidence in a Cream for 6 weeks!

"I’ve already spent over £4,000 and wasted so much time at beauty salons, but the results weren’t noticeable. Then my friend recommended 𝐙𝐯𝐨𝐞𝐯𝐨® Confidence in a Cream to reduce wrinkles, and I thought I should give it a try since I was almost out of what I had been using. To my surprise, I noticed my skin became brighter and firmer. After about six tubes, my skin continued to brighten, and my wrinkles and skin laxity improved a lot! I will definitely keep using it to bring my skin back to a more ideal state!" – Alicia Michaels, London

"I was a bit hesitant at first about using this wrinkle cream because I have sensitive skin. I reached out to customer service to confirm if it was safe, and they assured me it was suitable for sensitive skin. After doing a small patch test with no reaction, I decided to give it a shot. To my surprise, 𝐙𝐯𝐨𝐞𝐯𝐨® Confidence in a Cream really works wonders! It's the best value among all my skincare products. The photo I took after four weeks shows my skin looking almost as good as my friends who are ten years younger. My wrinkles have significantly reduced, and my skin feels much smoother. The fine lines around my lips have lessened too, so I no longer look like I have a mustache, which makes me really happy! I’m excited to keep using it to maintain a more youthful appearance!" – Patrick Taylor, Manchester
 "I've been searching for an effective solution for my under-eye bags until I stumbled upon this wrinkle cream. On my doctor's recommendation, I started using it. After just three weeks, my under-eye bags were noticeably gone, and the laugh lines had faded. I look more energized and refreshed! The skin around my eyes has become firmer, and the fine lines have greatly improved—I am so surprised by the results! I’ve decided to continue using this product to maintain this great condition, and I wholeheartedly recommend it to anyone with similar concerns!" — Veronica Kroll, Birmingham
"I've been searching for an effective solution for my under-eye bags until I stumbled upon this wrinkle cream. On my doctor's recommendation, I started using it. After just three weeks, my under-eye bags were noticeably gone, and the laugh lines had faded. I look more energized and refreshed! The skin around my eyes has become firmer, and the fine lines have greatly improved—I am so surprised by the results! I’ve decided to continue using this product to maintain this great condition, and I wholeheartedly recommend it to anyone with similar concerns!" — Veronica Kroll, Birmingham
Over 800,000+ users trust 𝐳𝐯𝐨𝐞𝐯𝐨® – Instant Refund if Not Satisfied!

Warning Signs of Skin Aging:
As we age, collagen, hyaluronic acid, and ceramides decrease, especially after 30. This decline leads to wrinkles, dryness, uneven skin tone, and loss of elasticity. Eyelids and facial muscles also sag, and neck wrinkles become more noticeable, accelerating the aging process.
This is exactly why we created 𝐙𝐯𝐨𝐞𝐯𝐨® Confidence in a Cream—to provide a gentle, effective solution for sensitive skin that helps restore firmness, smooth wrinkles, and maintain youthful, radiant skin in 2025.

𝐙𝐯𝐨𝐞𝐯𝐨® Confidence in a Cream uses high-quality ingredients to maximize efficacy by locking in moisture, stimulating collagen production, smoothing wrinkles, and repairing damage, suitable for sensitive skin.


𝐙𝐯𝐨𝐞𝐯𝐨® Confidence in a Cream uses gentle, skin-friendly ingredients suitable for sensitive skin to relax facial muscles and reduce the formation of expression lines. At the same time, hyaluronic acid deeply hydrates the skin, making it plump and effectively smoothing fine lines and wrinkles. The combination of Acetyl Hexapeptide-8 and other peptide technology targets deep wrinkles like forehead lines and crow's feet, leaving your skin looking firmer and smoother.
Visibly Reduces Dark Spots and Wrinkles

𝐙𝐯𝐨𝐞𝐯𝐨® Confidence in a Cream stimulates collagen production and firms the skin, helping to smooth wrinkles while visibly reducing dark spots. Its gentle peptide technology relaxes facial muscles and lifts sagging areas, reshaping youthful, well-defined facial lines. Rich hydrating ingredients lock in moisture, keeping the skin plump, radiant, and smooth, making your complexion appear brighter and more even, with a natural glow—suitable for sensitive skin.
Reveals Radiant Skin
𝐙𝐯𝐨𝐞𝐯𝐨® Confidence in a Cream combines cutting-edge technology with gentle, skin-friendly ingredients suitable for sensitive skin to specifically target and deeply repair drooping eyelids. Unlike typical products on the market, 𝐙𝐯𝐨𝐞𝐯𝐨® not only stimulates collagen production to enhance the elasticity of the delicate skin around the eyes but also uses advanced peptide technology to mimic the effects of Botox. This relaxes the muscles around the eyes and lifts sagging eyelids. The unique formula penetrates deep into the skin, promotes blood circulation, and, together with hyaluronic acid's deep moisturizing effects, makes the skin around your eyes plump and full. This effectively reduces drooping eyelids, giving your eyes a youthful, firm appearance. Choose 𝐙𝐯𝐨𝐞𝐯𝐨® to experience true skincare innovation and completely say goodbye to drooping eyelids.
Potent Ingredients with Instant Effects:

4% Niacinamide: Niacinamide helps to visibly brighten skin, improve uneven skin tone, and strengthen the skin barrier. It also reduces the appearance of fine lines and wrinkles while soothing and protecting sensitive skin.
Squalane: Squalane is a deeply moisturizing, lightweight oil that locks in hydration, softens the skin, and restores suppleness and elasticity without clogging pores.
Peptide-Lipid Complex: This advanced complex supports collagen and elastin production, firms the skin, smooths fine lines, and helps maintain youthful contours while being gentle on sensitive skin.

🧑⚕️Recommended by dermatologists & clinically proven

 The UK’s leading dermatologists consider 𝐙𝐯𝐨𝐞𝐯𝐨® Confidence in a Cream a breakthrough in at-home anti-aging skincare. Supported by clinical studies and recognised by respected dermatological associations, regular use has been proven to reduce fine lines and wrinkles, improve skin firmness, and promote a smoother, healthier, and more radiant complexion. Experts across the UK recognise it as a safe, gentle, and non-invasive alternative to costly professional treatments — making high-quality anti-aging skincare accessible to everyone, including those with sensitive skin.
The UK’s leading dermatologists consider 𝐙𝐯𝐨𝐞𝐯𝐨® Confidence in a Cream a breakthrough in at-home anti-aging skincare. Supported by clinical studies and recognised by respected dermatological associations, regular use has been proven to reduce fine lines and wrinkles, improve skin firmness, and promote a smoother, healthier, and more radiant complexion. Experts across the UK recognise it as a safe, gentle, and non-invasive alternative to costly professional treatments — making high-quality anti-aging skincare accessible to everyone, including those with sensitive skin.
Instructions for Use

Specification
𝐙𝐯𝐨𝐞𝐯𝐨® Confidence in a Cream (1/2/4/6 Jars).
Origin: UK
Shelf life: 3 years
We support Global Delivery 💡 Tip: Apply 𝐙𝐯𝐨𝐞𝐯𝐨® twice daily — morning and evening. Stay consistent, and watch fine lines, wrinkles, and dark spots gradually fade, leaving your skin firmer, smoother, and more radiant.
💡 Tip: Apply 𝐙𝐯𝐨𝐞𝐯𝐨® twice daily — morning and evening. Stay consistent, and watch fine lines, wrinkles, and dark spots gradually fade, leaving your skin firmer, smoother, and more radiant.

 🚚 Fast & Reliable UK Delivery
🚚 Fast & Reliable UK Delivery
We work with leading UK courier services including Royal Mail, DPD, and Evri to ensure your order arrives quickly, safely, and on time.
-
Same-Day Dispatch: Orders placed before 2pm (Mon–Fri) are usually dispatched the same day.
-
Express Shipping Options: Available at checkout for faster delivery when you need it sooner.
-
Fully Trackable: All parcels come with tracking numbers so you can monitor your delivery every step of the way.
-
Weekend & Evening Deliveries: Selected services may offer weekend or late-day delivery options for added convenience.
-
Eco-Friendly Packaging: We are committed to sustainability by using recyclable and minimal packaging wherever possible.
-
International Shipping: We also ship worldwide with reliable international courier partners—estimated delivery times and tracking available at checkout.